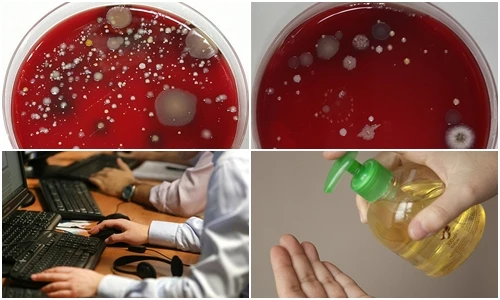
Ảnh dựng tóc gáy về vi khuẩn gây bệnh trong phòng làm việc

Trong những khoảnh khắc gia đình được chia sẻ, 'công chúa nhỏ' của Cao Minh Đạt và Trúc Trương gây chú ý bởi vẻ ngoài bụ bẫm, ngủ ngoan trong vòng tay bố mẹ.
Từng được kỳ vọng lật đổ iPhone, nhiều mẫu smartphone đình đám như Galaxy Note 7, BlackBerry Storm hay Amazon Fire Phone lại tự khai tử chính mình.
Từ sau 28/2, 3 con giáp này đón nhận vận may tài chính, cơ hội kiếm tiền và sự thịnh vượng tràn đầy.
Ở tuổi 24, Eric Tse bất ngờ bước vào hàng ngũ tỷ phú USD khi được gia đình chuyển giao khối cổ phần trị giá hàng tỷ USD.
Viện nghiên cứu chiến tranh của Mỹ (ISW) cho rằng, người Nga sẽ không tấn công Konstantinovka, mà thay vào đó sẽ tạo ra một "vũng lầy" tại đây.
Ngôi nhà vườn gây ấn tượng với vẻ đẹp bình dị trong khung cảnh nông thôn nhưng không kém phần hiện đại.
Mang vẻ ngoài khác lạ, chim di Araripe (Antilophia bokermanni) nổi bật như một biểu tượng mong manh của đa dạng sinh học và nỗ lực bảo tồn khẩn cấp.
Bên rìa sa mạc và dãy núi Atlas hùng vĩ, Ait-Ben-Haddou Ksar (Morocco) hiện lên như một pháo đài đất nung cổ tích, lưu giữ dấu ấn lịch sử suốt nhiều thế kỷ.
Google nâng cấp Circle to Search trên Galaxy S26 với khả năng nhận diện đa vật thể và tích hợp thử đồ ảo, mở rộng mạnh mẽ tìm kiếm trực quan Android.
Bộ trưởng Quốc phòng Pakistan Khawaja Mohammad Asif tuyên bố nước này đã hết kiên nhẫn và đang trong một "cuộc chiến công khai" với Afghanistan.
Các nhà khảo cổ học ở Ba Lan đã khai quật một ngôi mộ tập thể chứa hài cốt của 18 lính dù Đức quốc xã chết trong Chiến tranh thế giới 2.
Trong những khoảnh khắc gia đình được chia sẻ, 'công chúa nhỏ' của Cao Minh Đạt và Trúc Trương gây chú ý bởi vẻ ngoài bụ bẫm, ngủ ngoan trong vòng tay bố mẹ.
Phương Anh Đào lớn lên trong hoàn cảnh khó khăn. Lần hiếm hoi chia sẻ chuyện tình cảm, cô cho biết bản thân từng muốn kết hôn năm 18 tuổi.
Tại Hồ Bắc, Trung Quốc, robot đặc biệt đã thay thế con người sửa chữa đường dây 10 kV đang mang điện, đánh dấu bước tiến lớn về an toàn ngành điện.
Theo tử vi 12 cung hoàng đạo ngày 28/2, Cự Giải khi quý nhân xuất hiện giúp sự nghiệp thăng tiến. Bảo Bình năng lượng tích cực, mọi việc suôn sẻ
Trấn Thành liên tục pha trò phía sau ống kính, Văn Mai Hương nhiều lần tạo dáng selfie cùng đồng nghiệp ở hậu trường phim "Thỏ ơi".
Toyota đã chính thức trình ra mắt Land Cruiser FJ 2026, đây được xem như bản thu nhỏ của dòng Land Cruiser danh tiếng với phong cách thiết kế retro đặc trưng.
Trong bộ trang phục thể thao tông hồng pastel ngọt ngào, hot girl Mai Hà Hoàng Yến khéo léo khoe trọn những đường cong cơ thể 'vạn người mê'.
Không chỉ là nơi ở, ngôi nhà còn có khả năng nuôi dưỡng cảm xúc, không phô trương, không cầu kỳ, đầy sâu lắng và nhân văn.
Trong 7 ngày tới, vận khí của một số con giáp có thể chuyển biến mạnh mẽ, mở ra bước ngoặt quan trọng về tiền bạc và sự nghiệp.
Giữa khung cảnh tuyết trắng xóa đậm chất cổ tích, nhan sắc trong trẻo nhưng không kém phần quyến rũ của Ngân Hà đã trở thành tâm điểm chú ý.